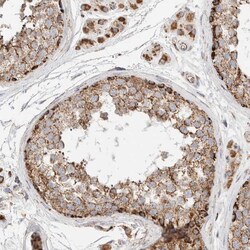

Antibody data
- Antibody Data
- Antigen structure
- References [1]
- Comments [0]
- Validations
- Immunocytochemistry [2]
- Immunohistochemistry [4]
Submit
Validation data
Reference
Comment
Report error
- Product number
- PA5-55318 - Provider product page

- Provider
- Invitrogen Antibodies
- Product name
- C1QBP Polyclonal Antibody
- Antibody type
- Polyclonal
- Antigen
- Recombinant protein fragment
- Description
- Immunogen sequence: GGWELELNGT EAKLVRKVAG EKITVTFNIN NSIPPTFDGE EEPSQGQKVE EQEPELTSTP NFVVEVIKND DGKKALVLDC HY Highest antigen sequence identity to the following orthologs: Mouse - 90%, Rat - 90%.
- Reactivity
- Human, Mouse, Rat
- Host
- Rabbit
- Isotype
- IgG
- Vial size
- 100 μL
- Concentration
- 0.10 mg/mL
- Storage
- Store at 4°C short term. For long term storage, store at -20°C, avoiding freeze/thaw cycles.
Submitted references Phylogenetically Defined Isoforms of Listeria monocytogenes Invasion Factor InlB Differently Activate Intracellular Signaling Pathways and Interact with the Receptor gC1q-R.
Chalenko Y, Kalinin E, Marchenkov V, Sysolyatina E, Surin A, Sobyanin K, Ermolaeva S
International journal of molecular sciences 2019 Aug 24;20(17)
International journal of molecular sciences 2019 Aug 24;20(17)
No comments: Submit comment
Supportive validation
- Submitted by
- Invitrogen Antibodies (provider)
- Main image

- Experimental details
- Immunofluorescent staining of C1QBP in human cell line A-431 using a C1QBP Polyclonal Antibody (Product # PA5-55318) shows localization to plasma membrane.
- Submitted by
- Invitrogen Antibodies (provider)
- Main image

- Experimental details
- Immunofluorescent staining of C1QBP in human cell line A-431 using a C1QBP Polyclonal Antibody (Product # PA5-55318) shows localization to plasma membrane.
Supportive validation
- Submitted by
- Invitrogen Antibodies (provider)
- Main image
- Experimental details
- Immunohistochemical analysis of C1QBP in human testis using C1QBP Polyclonal Antibody (Product # PA5-55318) shows strong granular cytoplasmic positivity in cells in seminiferous ducts and Leydig cells.
- Submitted by
- Invitrogen Antibodies (provider)
- Main image

- Experimental details
- Immunohistochemical analysis of C1QBP in human colon using C1QBP Polyclonal Antibody (Product # PA5-55318) shows strong granular cytoplasmic positivity in glandular cells.
- Submitted by
- Invitrogen Antibodies (provider)
- Main image

- Experimental details
- Immunohistochemical analysis of C1QBP in human kidney using C1QBP Polyclonal Antibody (Product # PA5-55318) shows strong granular cytoplasmic positivity in cells in tubules.
- Submitted by
- Invitrogen Antibodies (provider)
- Main image

- Experimental details
- Immunohistochemical analysis of C1QBP in human lymph node using C1QBP Polyclonal Antibody (Product # PA5-55318) shows strong granular cytoplasmic positivity in non-germinal and germinal center cells.
 Explore
Explore Validate
Validate Learn
Learn Western blot
Western blot Immunocytochemistry
Immunocytochemistry